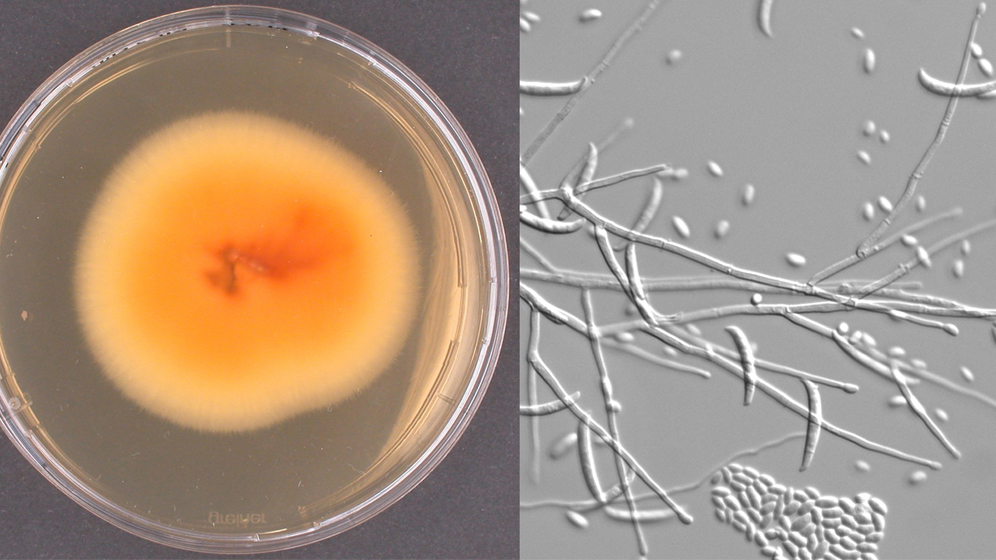
Kultur_und_mikroskopische_Aufnahme_Fusarium_spp_NRZ_Myk_HKI.jpg Fusarium spp.

Mehr als drei Millionen Erwachsene in Deutschland tragen nach Zahlen des Instituts für Demoskopie Allensbach Kontaktlinsen. Den wenigsten davon ist bewusst, dass bei falschem Umgang und mangelnder Hygiene ein hohes Risiko für Infektionen der Hornhaut (Keratitis) und andere Komplikationen besteht. Aus diesem Grund hatte die amerikanische CDC im Rahmen der Contact Lens Health Week in den USA über den richtigen Umgang mit Kontaktlinsen berichtet.
Oft Schimmelpilze nachgewiesen
Das Nationale Referenzzentrum für Invasive Pilzinfektionen NRZMyk hat diese Kampagne unterstützt. Daten des NRZMyk zeigen, dass auch in Deutschland Bedarf für weitere Forschungsarbeiten und bessere Information von Kontaktlinsenträgern und Ärzten besteht. Allein am NRZMyk wurden in den letzten zwölf Monaten in 30 Fällen von kontaktlinsenassoziierter Keratitis Schimmelpilze nachgewiesen. Die Pilzkeratitis ist eine besonders schwerwiegende Form der Hornhautentzündung. Sie tritt vor allem bei Kontaktlinsenträgern auf - insbesondere bei der Verwendung von sogenannten weichen Kontaktlinsen.
Patienten bemerken eine Keratitis meist durch eine starke Rötung des Auges, teils erhebliche Schmerzen und eine Sehverschlechterung.
Eine kontaktlinsenassoziierte Keratitis sollte immer ernstgenommen werden und umgehend ein Augenarzt aufgesucht werden. Experten des NRZMyk warnen dabei insbesondere vor der Pilzkeratitis: „Oft handelt es sich um hochresistente Erreger, die nur schlecht auf eine medikamentöse Therapie ansprechen – in schweren Fällen wird eine Hornhauttransplantation erforderlich, teilweise droht der Verlust des gesamten Auges“, erläutert Prof. Marie von Lilienfeld-Toal, die sich intensiv mit den Keratitisfällen beschäftigt, die am NRZMyk diagnostiziert wurden.
Nationales Register für Pilzkeratitiden
Bislang liegen keine Infektionszahlen für Deutschland vor. Die Experten des NRZMyk haben daher gemeinsam mit der Augenklinik des Universitätsklinikums Düsseldorf ein nationales Register für Pilzkeratitiden eingerichtet (www.pilzkeratitis.de). „In diesem Register wollen wir klinische Informationen zu Pilzkeratitiden in Deutschland erfassen. Unter anderem soll analysiert werden, welche Therapien besonders erfolgreich sind und mit welchen Erregern wir es überhaupt zu tun haben.“, erklärt Prof. Oliver Kurzai, Leiter des NRZMyk.
Ziel ist es, künftig bessere Empfehlungen zur Vermeidung solcher Infektionen und zu ihrer Behandlung geben zu können. Dazu erfolgt am Referenzzentrum eine umfassende molekularbiologische und mikrobiologische Charakterisierung aller Erreger. Gleichzeitig erfassen die Spezialisten um Prof. Geerling in Düsseldorf alle wichtigen klinischen Informationen und werten sie aus.
Informationen werden benötigt
Die beteiligten Ärzte sind sich einig, dass dringend mehr Informationen zu diesen gefährlichen und schlecht zu behandelnden Infektionen benötigt werden. Daher hat das Nationale Referenzzentrum die Kampagne der amerikanischen CDC, die dieses Jahr unter dem Motto “Healthy habits mean healthy eyes” (zu deutsch etwa: „gesunde Gewohnheiten sorgen für gesunde Augen“) stand, unterstützt. Dieses Motto gilt nach Überzeugung der Experten vom NRZMyk ganz besonders auch für die Pilzkeratitis: „Nach allem was wir wissen, kann durch eine konsequente Einhaltung von Hygieneregeln im Umgang mit Kontaktlinsen und Spülflüssigkeit das Infektionsrisiko für Kontaktlinsenträger erheblich gesenkt werden – und das ist gerade bei Pilzinfektionen wegen der oft dramatischen Folgen für die Patienten ungeheuer wichtig“. (idw, red)
Hintergrundinformationen:
Nationale Referenzzentren (NRZ) werden zur Überwachung wichtiger Infektionserreger benannt und durch das Robert Koch-Institut in Abstimmung mit dem Bundesministerium für Gesundheit berufen. Das NRZ für Invasive Pilzinfektionen (NRZMyk) ist als eines von 19 NRZ Ansprechpartner für Ärzte und Mikrobiologen aus ganz Deutschland bei Fragen zur Diagnostik und Behandlung invasiver Pilzinfektionen. Neben einer gezielten Beratung bietet das NRZMyk auch spezielle diagnostische Verfahren zum Nachweis von invasiven Pilzerkrankungen an und beobachtet die Epidemiologie von Pilzinfektionen in Deutschland, um so frühzeitig das Auftreten neuer Erreger oder mögliche Resistenzentwicklungen zu erkennen. Dabei kooperiert das NRZMyk mit anderen Referenzlabors weltweit. Das NRZMyk wird von Prof. Dr. med. Oliver Kurzai geleitet und ist am Leibniz-Institut für Naturstoff-Forschung und Infektionsbiologie – Hans-Knöll-Institut – in Jena angesiedelt.
Artikel teilen